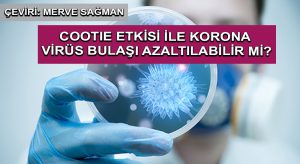
COOTIE ETKİSİ İLE  KORONA VİRÜS BULAŞI AZALTILABİLİR Mİ?

Düğünlerde israfı önlemeliyiz

1920’de “Düğünlerde Men-‘i İsrâfât Kanunu” Çıkarıldı
Erkek ve kadının hayatlarını birleştirerek hayırlı bir nesli dünyaya getirmek için aralarında yaptıkları akde nikâhdenir (“nikah akdi” kullanımı için bkz. Bakara 235, 237). Bu akdin ilanı ve akraba ile kutlanması da düğünolarak isimlendirilir Anadolu topraklarında. Düğüne çağırılacak kimselere davet gönderilerek düğünün zamanı ve mekânı haber verilir. Buna “düğüne okumak” denir. Okumanın, çağırmak yerine kullanılması Kur’ân dilinde de benzer bir kullanımın bulunması sebebinden ileri geliyor olabilir (Bkz. قرأ kökü).
Düğüne iştirak edenler gelin ile güveyi tebrik ederek dünyaya gelecek yeni nesil için hayır dualarda bulurlar ve velîmedenilen düğün yemeğinden yerler. Bu yemek, yörenin geleneklerine göre hazırlanır ve ikram edilir. Durumu iyi olanlar da kötü olanlar da durumlarına göre ikramda bulunurlar. Râsul-i Ekrem durumu iyi olmayan ashabına ıslak hurma yahut bir koyun ile de olsa düğün yemeği vermelerini tavsiye etmiştir.
Düğünlerde çalgı çengi de olabilir. Râsul-i Ekrem davet edildiği düğünlerde çalgının olup olmadığını hassaten sorar, çalgılı düğünlerdeki memnuniyetini izhar ederdi. Hatta O, “nikâhı def ile de olsa ilan ediniz”buyurarak çalgının nikâhı ilan etmedeki yerini ifade etmiştir. Anadolumuzda da davul, zurna ile düğünlerimiz ilan edilir ve halk oyunları oynanır.
Görüldüğü üzere düğünün iki temel unsuru ilânve ikramdır. Bunlar gerçekleştirilirken israfa kaçılmaması yine dinimizin emirlerindendir (Enam 141, Araf 31). Milli sermayenin çarçur edilmesinin önüne geçmek için 25 Kasım 1920’de “Düğünlerde Men-‘i İsrâfât Kanunu”nun kabul edildiğini de hatırlamak gerekir. Bu kanuna göre iki kattan fazla elbise ihdası, bir günü aşan düğünlerde çalgı ve ikram, nişan, çevre merasimi ve köçek oynatılması yasaklanmış; hilafına davranışta bulunanlar elliden yüz liraya kadar nakdî para ve bir aydan altı aya kadar hapis ile cezalandırılmıştır.
Günümüzdeki düğünlerde gelin yahut güveyin durumu göz önüne alınmaksızın aileler tarafından en iyisi olsun istenmektedir. Durumu iyi olanların ultra lüksdüzenlediği düğün törenleri işi övünme ve caka satmaya boğmaktan öte bir şeye yaramamaktadır.Temeli israf ile atılan evliliğin sonunun nereye varacağını Allah bilir. Damadın düğün elbisesinin akrabadan ödünç alındığı düğünlerle, gelinlik ve damat takımına servet ödendiği düğünlerin saadetle ilişkisi kurulacak olsa ters bir orantının söz konusu olduğu genel itibariyle söylenebilir.Dini düsturların düğün ve evlerin tefrişatında es geçildiğini bugün herkes görmekte ancak ses çıkarmamaktadır. Hz. Fatıma’nın perdesinitekrar hatırlamakta fayda var:
Râsul-i Ekrem âdeti olduğu üzere herhangi bir seferden döndüğünde önce kızına uğrar sonra eşlerini ziyaret ederdi. Hz. Fatıma’nın kapısında süslü bir perde görünce eve girmekten vazgeçmiş bu da Hz. Fatıma’yı çok üzmüştü. Hz. Ali bunun sebebini Rasûl-i Ekrem’e sorduğunda şöyle cevaplamışlardı: “Evinizin kapısında renk renk nakışlarla süslü bir perde gördüm. Benim öyle süslü püslü şeylerle, nakışlarla işim olmaz.”
Gelişen Olaylara İslami Bakışın Adresi